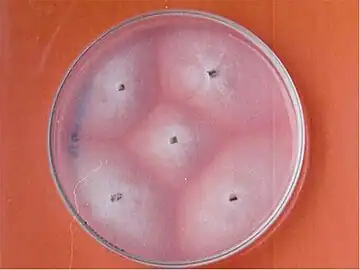
Geotrichum candidum culture

Geotrichosis
| Geotrichosis | |
|---|---|
| Other names: Geotrichoses[1] | |
  | |
| |
| Specialty | Infectious disease |
| Symptoms | Symptoms vary depending on the affected area |
| Causes | Geotrichum candidum [2] |
| Diagnostic method | Skin scrapings[3][2] |
| Differential diagnosis | Tuberculosis, Cryptococcosis, Histoplasmosis,Blastomycosis[3] |
| Treatment | Amphotericin B, itraconazole, or topical nystatin [4] [5] |
Geotrichosis is a mycosis caused by Geotrichum candidum. Geotrichum candidum is also a frequent member of the human microbiome, notably associated with skin, sputum and feces where it occurs in small to moderate percent of specimens. The fungus can cause an infection known as geotrichosis, affecting the oral, bronchial, skin and bronchopulmonary epithelia. The inoculum may arise from endogenous or exogenous sources. [6][7]: 311 [8]
Most cases affect the bronchopulmonary tree, although other sites can be involved, such as oral mucosa and vagina. Skin and gut infections are also known. Reported cases of geotrichosis have been characterized with symptoms of chronic or acute bronchitis. Exogenous geotrichosis may arise from contact with contaminated soil, fruits or dairy products.[9][10]
Types
- Pulmonary geotrichosis is the most frequent form of geotrichosis. The symptoms appear to be secondary symptoms of pulmonary disease. This includes symptoms such as light, thick, sputum. Patients often have a cough that produces clear or yellow sputum. Another symptom of pulmonary geotrichosis includes fine to medium rales. The condition appears chronic with the presence of a little debilitation, fever and occasional wheezing can occur.[11][12][1][13]
- Bronchial geotrichosis does not involve the lung instead the disease persists within the bronchial. Geotrichum candidum grows in the lumen of the bronchi. The disease is characterized as an endobronchial infection. Bronchial geotrichosis is similar to the allergic reaction of aspergillosis. Symptoms include prominent chronic cough, gelatinous sputum, lack of fever and medium to coarse rales. Patients with the bronchial condition their pulse and respiration are rarely elevated.Colonization of the bronchi can be associated with Candida albicans and usually occur with patients with chronic obstructive lung disease.[14][15][16]
- Oral and vaginal geotrichosis is similar to thrush in its appearances and was often confused with this infection. The infected area forms a white plaque and patients usually report burning sensation in the affected areas. The vaginal geotrichosis is more common in pregnant women and is often associated with vaginitis.[17][1][2][18]
- Gastrointestinal geotrichosis is a specific type of fungal infection that affects the digestive tract. It is caused by the yeast-like fungus Geotrichum candidum, which is a common inhabitant of the human gut as part of the normal flora,however under certain conditions, it can become pathogenic[19]
- Cutaneous geotrichosis has two different types of variants which include superficial and deep infection. The superficial form the infection occurs on skin folds including submammary, inguinal, perianal and interdigital folds. The deep form develops nodules, and ulcers on legs, face and hands.[17] [2]
Cause

Geotrichum candidum belongs to the Ascomycota division and typically forms white, flat, suede-like colonies. Microscopically, it produces hyaline, septate hyphae that fragment into chains of arthroconidia—its asexual spores.G. candidum is also an opportunistic pathogen[20]
Diagnosis
The diagnoses of geotrichosis cannot be determined without using culture or microscopic measurements. The laboratory diagnosis of geotrichosis involves collected fungi samples areas of infections without contamination. Scraping of the mouth lesions and the ulcers can provide a sample of G. candidum. Samples can also be collected from pus and mucus can be obtained from the feces. Sputum can be searched for the mucoid-like white flakes for further examination. Culturing the cylindrical barrel-shaped or elliptical fungi in considerable numbers in oral lesions is an indicator that a patient may have geotrichosis.[3][2][21][15]
X-rays or CT scans can be used to examine the lung tissue, however it can not be used to positively diagnose geotrichosis. X-rays or CT scans may show cavitation that is located the walls of the lungs tissues. The results of imaging of pulmonary geotrichosis presents smooth, dense patchy infiltrations and some cavities.[3][12][3]
-
Geotrichum candidum culture
Geotrichum candidum culture -
 CT scan thorax revealed a soft-tissue mass with cavitation and surrounding consolidation at the right upper lobe
CT scan thorax revealed a soft-tissue mass with cavitation and surrounding consolidation at the right upper lobe
Differential diagnosis

In terms of the DDx we find that each type is different; however Pulmonary Geotrichosis is the most frequent form, therefore the following should be included:[3][12][4]
- Tuberculosis
- Cryptococcosis
- Histoplasmosis
- Blastomycosis
- Coccidioidomycosis
- Bacterial pneumonias
- Nocardiosis
Prevention
As to prevention a few things can be done to help prevent Geotrichosis, they are:[22]
- Clean and dry skin, especially in areas prone to moisture accumulation like skin folds
- Avoid prolonged exposure to humid environment
Treatment

There is no standard treatment for geotrichosis,there are several types of antimicrobial or antifungal compounds that can be used for geotrichosis treatment.Azole drugs including isoconazole and clotrimazole are used for geotrichosis treatment.[4] [5]
Amphotericin B, clotrimazole and S-fluorocytosine have become more susceptible to G. candidum. Antimycotic resistance can appear due to repeated treatment.[5]
Epidemiology
As to the epidemiology of Geotrichosis we find that it is geographically widespread, with indications that in the United States, Germany, and India have more reported cases[2]
History
In 1847 Bennett described Geotrichum candidum causing a superinfection in the tuberculous cavity. Bennett was able to differentiate infection by Geotrichum candidum from candidiasis, and diagnose the first case of geotrichosis.[23]
Notes
- 1.^ This is a case study(or case studies)
References
- ↑ 1.0 1.1 Bonifaz, Alexandro; Vázquez-González, Denisse; Macías, Berenice; Paredes-Farrera, Fernando; Hernández, Marco A.; Araiza, Javier; Ponce, Rosa M. (September 2010). "Oral geotrichosis: report of 12 cases". Journal of Oral Science. 52 (3): 477–483. doi:10.2334/josnusd.52.477. ISSN 1880-4926. PMID 20881343. Archived from the original on 2025-02-02. Retrieved 2025-06-21.
- ↑ 2.0 2.1 2.2 2.3 2.4 2.5 Román-Montes, Carla M.; Sifuentes-Osornio, José; Martínez-Gamboa, Areli (1 March 2024). "Cutaneous Infections by Geotrichum spp". Current Fungal Infection Reports. 18 (1): 60–68. doi:10.1007/s12281-024-00481-9. ISSN 1936-377X. Archived from the original on 20 August 2024. Retrieved 18 June 2025.
- ↑ 3.0 3.1 3.2 3.3 3.4 Kayser, Klaus (6 December 2012). Analytical Lung Pathology. Springer Science & Business Media. p. 174. ISBN 978-3-642-48727-9.
- ↑ 4.0 4.1 Kwon-Chung, K.J.; Bennett, J.E.; Bennett, John E. (1992). Medical mycology. Philadelphia: Lea & Febiger. ISBN 0812114639.
{{cite book}}: CS1 maint: multiple names: authors list (link) - ↑ 5.0 5.1 5.2 Pottier, I.; Gente, S.; Vernoux, J. P.; Gueguen, M. (2008). "Safety Assessment of Dairy Microorganisms: Geotrichum candidum". International Journal of Food Microbiology. 126 (3): 327–332. doi:10.1016/j.ijfoodmicro.2007.08.021. PMID 17869364.
- ↑ "Geotrichum candidum - Knowledge and References". Taylor & Francis. Retrieved 30 June 2025.
- ↑ James, William D.; Berger, Timothy G.; et al. (2006). Andrews' Diseases of the Skin: clinical Dermatology. Saunders Elsevier. ISBN 0-7216-2921-0.
- ↑ Suhonen, Raimo E.; Dawber, Rodney P. R.; Ellis, David H. (10 September 2020). Fungal Infections of the Skin and Nails. CRC Press. p. 22. ISBN 978-1-000-14896-1.
- ↑ Boutrou, R; Gueguen, M (2005). "Interests in Geotrichum candidum for Cheese Technology". International Journal of Food Microbiology. 102 (1): 1–20. doi:10.1016/j.ijfoodmicro.2004.12.028. PMID 15924999.
- ↑ Ghannoum, Mahmoud A.; Perfect, John R. (8 March 2019). Antifungal Therapy, Second Edition. CRC Press. ISBN 978-0-429-68769-3. Retrieved 8 July 2025.Google books offers no page
- ↑ El-Hassani, I.; Deham, H.; Touaoussa, A.; Er-rami, M. (1 December 2014). "Infection pulmonaire à Geotrichum capitatum à propos d'un cas et revue de la littérature". Journal de Mycologie Médicale. 24 (4): 341–344. doi:10.1016/j.mycmed.2014.10.001. ISSN 1156-5233. PMID 25458367.
- ↑ 12.0 12.1 12.2 Ghosh, Purbasha; Boler, Anup Kumar (November 2020). "Geotrichum candidum: A rare primary pathogen in pulmonary geotrichosis". The Indian Journal of Medical Research. 152 (Suppl 1): S123 – S124. doi:10.4103/ijmr.IJMR_2202_19. ISSN 0975-9174. PMC 8257100. PMID 35345161.
- ↑ Winer-Muram, Helen T. (1 December 1988). "Geotrichosis: Who is Susceptible?". Chest. 94 (6): 1315–1316. doi:10.1378/chest.94.6.1315b. ISSN 0012-3692. PMID 3191781. Retrieved 8 July 2025.
- ↑ Baker, Roger Denio; Angulo, O. A.; Barroso-Tobila, C.; Carbonell, L. M.; Cespedes, R.; Chick, E. W.; Clark, B. M.; Duque, O.; Edington, G. M.; Fetter, B. F.; Graham, J. H.; Guidry, D. J.; Huntington, R. W. Jr; Ichinose, H.; Klintworth, G. K.; Lurie, H. I.; Mohapatra, L. N.; Morenz, J.; Nielsen, H. S. Jr; Parker, J. C. Jr; Pena, C. E.; Pizzolato, P.; Pollak, L.; Salfelder, K.; Schwarz, J.; Wiersema, J. P.; Winner, H. I.; Winslow, D. J. (6 December 2012). The Pathologic Anatomy of Mycoses: Human Infection with Fungi, Actinomycetes and Algae. Springer Science & Business Media. p. 935. ISBN 978-3-642-80570-7.
- ↑ 15.0 15.1 Dail, David H.; Hammar, Samuel P. (29 June 2013). Dail and Hammar's Pulmonary Pathology. Springer Science & Business Media. p. 238. ISBN 978-1-4757-3932-9.
- ↑ Yousfi, F; Guerrouj, S; Taghlaoui, R (2021). "Infectious pneumonia due to Geothricum Candidum: A case report and review of the literature" (PDF). Journal of Functional Ventilation and Pulmonology. 37 (12). doi:10.12699/jfvpulm.12.37.2021.74 (inactive 14 July 2025). Retrieved 13 July 2025.
{{cite journal}}: CS1 maint: DOI inactive as of July 2025 (link) - ↑ 17.0 17.1 Vázquez-González, Denisse; Perusquía-Ortiz, Ana María; Hundeiker, Max; Bonifaz, Alexandro (2013). "Opportunistic Yeast Infections: Candidiasis, Cryptococcosis, Trichosporonosis and Geotrichosis". JDDG: Journal der Deutschen Dermatologischen Gesellschaft. 11 (5): 381–394. doi:10.1111/ddg.12097. PMID 23621330.
- ↑ Kantardjiev, T.; Kuzmanova, A.; Baikushev, R.; Zisova, L.; Velinov, T. (1998). "Isolation and identification of Geotrichum candidum as an etiologic agent of geotrichosis in Bulgaria". Folia Medica. 40 (4): 42–44. ISSN 0204-8043. PMID 10371798.
- ↑ Pal, Mahendra; Sejra, Sunita; Sejra, Anand; Tesfaye, Sihin (2013). "Geotrichosis - An Opportunistic Mycosis of Humans And Animals". International Journal of Livestock Research. 3 (2): 38. doi:10.5455/ijlr.20130525092525.
- ↑ Eliskases-Lechner, F. (1 January 2002). "GEOTRICHUM CANDIDUM". Encyclopedia of Dairy Sciences. Elsevier. pp. 1229–1234. ISBN 978-0-12-227235-6.
- ↑ Sprute, Rosanne; Cornely, Oliver A.; Chen, Sharon C.-A.; Seidel, Danila; Schuetz, Audrey N.; Zhang, Sean X. (31 August 2021). "All You Need To Know and More about the Diagnosis and Management of Rare Yeast Infections". mBio. 12 (4): e01594-21. doi:10.1128/mBio.01594-21. ISSN 2150-7511. PMC 8406212. PMID 34425700.
- ↑ Loukou, Evangelia; Jensen, Nickolaj Feldt; Rohde, Lasse; Andersen, Birgitte (27 January 2024). "Damp Buildings: Associated Fungi and How to Find Them". Journal of Fungi (Basel, Switzerland). 10 (2): 108. doi:10.3390/jof10020108. ISSN 2309-608X. PMC 10890273. PMID 38392780.
- ↑ Moss, Emma Sadler; A.L. McQuown (1969). Atlas of Medical Mycology (3rd ed.). Baltimore, Md: The Williams & Wilkins Company. ISBN 978-0683060867.
{{cite book}}: CS1 maint: multiple names: authors list (link)Google scholar does not offer page
External links
| Classification |
|---|